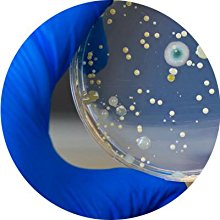

🧺 Stay fresh, stay fearless – hygiene that speaks louder than words!
Dettol Antibacterial Laundry Cleanser Liquid Additive kills 99.9% of bacteria even in cold water washes (as low as 15°C), with a quick 15-minute soak option to eliminate viruses. Dermatologically tested and available in a convenient multipack of four 1.5L bottles, it ensures your laundry is hygienically clean and safe for sensitive skin every time.

| Manufacturer | Dettol |
| Item model number | 3000839 |
| Package Dimensions | 29.8 x 28.69 x 19.8 cm; 1.66 kg |
| ASIN | B00FQHNDFG |
H**.
Confusing picture of the product on site
Good product but too expensive and also the picture of 4 bottles on site is confusing when only one bottle is being sent and recieved
P**I
Nice
Good
.**R
Clothing disinfectant
Good
A**S
Good to buy
Good and unique product
A**R
It's Okay
Thanks
N**I
Costly but love it
Really good for bedsheets, towels and sports clothes.
V**A
Always a great product. I love to use it for my ...
Always a great product.I love to use it for my clothes.
A**R
Awesome!
Best antibacterial fabric conditioner available in the market.
Trustpilot
1 week ago
1 week ago
5 days ago
1 month ago